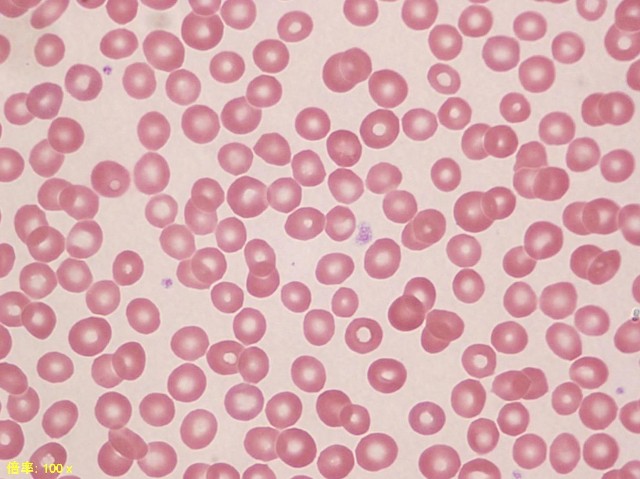
f:id:K88344193:20210214184818j:image

はたらく細胞とは Part3 白血球編 単球
はたらく細胞って漫画・アニメ知っていますか?(キャラと実際の細胞を比較・解説してみたPart 3:白血球編 単球)
今回は単球について比較・解説していきます
全白血球の約7%を占める単核の遊走細胞
他の免疫細胞同様、生体防御に関与する
はたらく細胞!! 公式
と公式では説明されています!
では、顕微鏡でみていきましょう…🔍!
http://www.beckmancoulter.co.jp/hematology/monthly_magazine/description/q_t02.html
特徴的な形をしていますよね!
単球は白血球の中で最も大きく、直径15~20μmあります(好中球は12~15μm)
核(紫色の部分)は腎臓の形や馬の蹄(ひずめ)の形に似ていることから腎臓型や馬蹄(ばてい)型と言わます
細胞質(薄い紫色の部分)は好中球よりも青みが強く(淡青灰色)染まり、空胞(白く抜ける部分)があることもあります
で単球さんは登場します是非チェックしてみてくださいね
単球の働き
血液中では、単球として存在しますが組織に移行すると、マクロファージになります!
顕微鏡…🔍!
(3:マクロファージ)
http://www.beckmancoulter.co.jp/hematology/monthly_magazine/description/q_t02.html
(組織内のマクロファージ HE染色)
https://www.msdconnect.jp/products/keytruda/tps-seminar-commentary1.xhtml
殺菌作用、異物の処理、血球の処理、免疫応答などなど様々な働きをしています
動きは好中球ほど速くはありませんがマクロファージは特に貪食能が強く細菌、真菌、原虫、ウイルスなどを貪食殺菌するとともに分解し
異物や原因物質をT細胞(リンパ球)に提示します
マクロファージは脾臓やリンパ節などにも存在していて脾臓では、老朽化した赤血球(寿命は120日)・血小板などを貪食、処理する働きもあります
樹状細胞も単球から分化した細胞です!
顕微鏡…🔍!
ラルフ・スタインマン博士が発見した樹状細胞(マウス)。
写真はJ Exp Med 1973;137:1142-1162より。
樹の枝のような細長い突起をいくつも持っている細胞なので樹状細胞と名付けられました
肺や皮膚、鼻腔など様々な組織に存在していて、異物を貪食、分解して抗原の提示、T細胞を活性化する働きを持っています
「あれ、マクロファージと同じ?」と思いますよね
マクロファージは主に貪食能
樹状細胞は、抗原提示に優れています
そのため、プロフェッショナル抗原提示細胞という別名もあります
まとめ
・単球は組織に入るとマクロファージになる
・マクロファージは貪食能に優れている
・樹状細胞は抗原提示のプロフェッショナル
・マクロファージや樹状細胞は抗原提示を行いT細胞を刺激、活性化する
単球について比較・解説してきましたいかがだったでしょうか?様々な働きがある細胞で免疫に深く関係していることが何となく分かっていただけたと思います!免疫系は大きく自然免疫と獲得免疫というものに分けられますが、好中球やマクロファージは※自然免疫に分類されます
※特異性は低いがとにかく早い(なんでもかんでも異物が入って来たらすぐに動く)
アニメでマクロファージや樹状細胞とT細胞達が一緒にいるシーンが多いなと感じませんか?
それはマクロファージや樹状細胞がT細胞へ抗原提示・活性化の働きを持っているからなんですね🙌🙌
そういうところにもチェックしてアニメや漫画を見ると面白いかもしれないですね👀
次回も宜しくお願いします!
はたらく細胞とは Part2 白血球編 好中球
はたらく細胞って漫画・アニメ知っていますか?(キャラと実際の細胞を比較・解説してみたPart 2:白血球編)
前回に引き続き白血球について擬人化のキャラと実際の細胞との比較をしていきたいと思います
今回は白血球編ということで
主人公枠である白血球の中でも好中球をピックアップしていきます🙌
主な仕事は外部から体内に侵入した細菌やウイルスなどの異物を排除すること。 好中球は血液中の白血球の半数以上を占める
公式ではこんな感じで紹介されています
では実際の細胞はどうなのか
顕微鏡で観察してみましょう…🔍
「あれ?全然白くないじゃん」って思いますよねこれは分類しやすいように染色しているからなんです(メイギムザ染色)
本当は白いんですよ!
膿とかも白いですよね、あれは細菌と戦って死んだ白血球の残骸だから白いんです👼
顕微鏡での画像を見てわかるように
好中球は桿状核球(幼若な好中球)と分葉核球(成熟した好中球)に分けられます
形状としては分葉核球核球は核(紫色の部分)が
2~5個に分葉している桿状核球は長い曲がった帯状の核を持っているので見分けることができます
正常な場合は分葉核球がほとんどですが感染症や急性炎症では桿状核球が出現してきます これは、急性的な炎症の場合に骨髄からの白血球の生産が間に合わないために急ピッチで生産された幼若な好中球が血液中に放出されるからです
まだ成熟しきっていないのに戦いに出されるイメージですかね…😭😭(左方移動)
基準値
白血球数(総数)の基準値は4000~8000/μLです
好中球の割合は 45~65%になります
白血球は、好中球、リンパ球、単球、、好酸球、好塩基球に大別できます
血液検査をしていてあれ?検査値高いなー?って思ってカルテを見てみるとやっぱり細菌感染症疑いとかの場合が多いですね 他にも白血球が上がる要因としては運動や喫煙なども考えられます検診などある場合は控えた方がいいかもしれないですね
好中球の働き
粘着能、遊走能、貪食能、殺菌処理があります
アニメでも、紹介されているように病原微生物などの異物が身体に侵入した時に貪食・殺菌していましたよね
はたらく細胞で、肺炎球菌が侵入した時にも好中球さんは大活躍でしたね!!
※ちなみに肺炎球菌を比較するとこうなります…🔍
https://www.nagasaki-clinic.com/_m/streptococcus_pneumoniae/
学名では、Streptococcus pneumoniae
(ストレプトコッカスニューモニエ)といいます分類としてはグラム陽性双球菌で白く抜けているのは莢膜のためです、難しいですよね…笑
いつか、細菌の話もできたらいいな🤔
まとめと今後について
こん感じで好中球について簡単に解説していきました
アニメ版の好中球さんかっこいいですよね
頑張れって応援したくなります
肺炎球菌は悪い顔してますね笑
白血球は好中球の他にも
リンパ球、単球、好酸球、好塩基球に大別できますので今後はそちらを比較解説して行けたらと思います
はたらく細胞 新キャラが続々登場してきて
さらにパワーアップして、面白くなっています!
是非、まだ見ていない方はチェックしてみ下さいね
はたらく細胞とは Part1 赤血球
はたらく細胞って漫画・アニメ知っていますか?(キャラと実際の細胞を比較・解説してみた)
アニメの第1期は2018年7月8日から9月30日まで放送されて2021年1月からは第2期とはたらく細胞BLACKが放送中です
これはあなたの物語。 あなたの体内からだの物語──。 人の細胞の数、およそ37兆個(新説)。 細胞たちは体という世界の中、 今日も元気に、休むことなく働いている。 酸素を運ぶ赤血球、細菌と戦う白血球……。 そこには、知られざる細胞たちのドラマがあった 誰もが共感できる、
体内細胞擬人化ストーリー
細胞達を擬人化させることで
とても分かりやすく、尚且つ楽しく勉強もできる学習アニメだと思います
このアニメが自分の学生時代に放送されていれば
血液学や微生物学がもっと楽しく勉強できたかも…🙄🙄?
最近、血液部門の担当になったので
また、学生時代の教科書を引っ張り出してきて 勉強しているんですが
赤血球や白血球を顕微鏡や画像集を見てるとはたらく細胞のキャラクターに見えてくるんですよね笑
今回は、実物の細胞とはたらく細胞に出てくる擬人化された細胞を比較して解説をしていきます
出てくるキャラクターが多いので少しづつやって行きます!
今回は、赤血球を比較して行きたいと思います

血液循環により、酸素を体中に届け、
二酸化炭素を肺に運搬する。
赤血球はヘモグロビンを多く含んでいるため赤い。
(公式参照)
「はたらく細胞」公式説明にもある通り
肺から酸素を取り込み、体の隅々の細胞に運び供給する役割を担い、また同様に二酸化炭素の排出を行います。
基準値は血液1µL(0.001mL)あたり
※スポイト1滴→約40μL
男性:435~555万個
女性:386~492万個
凄い数ですよね!!
アニメでは、擬人化してますので
1人1人ピックアップして描かれていますが
本当は満員電車のように血管内にギュウギュウです笑
赤血球の中央は凹になっているので
折れ曲がることができ、細い血管を通り抜けたり、血管から組織へ容易に抜け出やすくなっています。
寿命は約120日で、脾臓や肝臓などのマクロファージに捕捉され分解されます
健康診断などでは
赤血球数はRBCと略されています
※R:RED B:BLOOD C:Cell
それでは
顕微鏡でみた時はどう見えるのか見てみましょう…🔍
赤い丸の細胞が赤血球です
赤血球の大きさは約8μmです
この赤血球が血管内で細胞、臓器に酸素を運んで末端から二酸化炭素を肺に戻しているんです
24時間365日休みなく働いて120日で寿命を迎えると考えると
まさに、BLACK企業ですね笑
アニメにも出てきますが過度なアルコールの摂取や睡眠不足、喫煙など自分で自分を痛めつけてるんです。
細胞達が悲鳴を上げています😭pien
身体を労うって大切です
自分の身体をブラック企業にしないでくださいね笑
そして、この赤血球が少なくなることを
貧血といいます
貧血になると全身に酸素が送れなくなってしまうために立ちくらみ、息切れ、めまい、ふらつき、頭痛、胸の痛み、 動悸 、疲労感などの症状が出ることがあります
それを補うために輸血をすることもあります
貧血の理由は様々ありますが長くなるのでその話はまた、今度に🙌
どうですか?
何となく赤血球を身近に感じていただけましたでしょうか?
自分の身体をこの赤血球が巡っていると考えるとちょっと不思議ですよね🤔
自分は心臓の超音波検査も行っているんですが
血液を全身に送るポンプの役割を担っているの臓器が、心臓なんです!
本当に人の身体って面白いですよね!
こんな感じで、アニメに出てくる細胞達を
解説して行きたいと思います
漫画・アニメも
これを機会に是非読んでいただけたらと思います!
アニメ、「はたらく細胞!!」「はたらく細胞BLACK」は絶賛放送中です!
ではまた、宜しくお願いします
どうして血液検査は時間がかかるのか?
具合が悪いのに病院で、何時間も待たされた経験皆さん1度はありますよね?
どうして時間がかかるんでしょう?
外来が混雑していて患者さんの人数が多いために診察が長くなることや
レントゲン、MRI、超音波検査の順番待ちで時間がかかったり
様々な理由が考えられますよね
でも、検査技師をしていて患者さんに言われるのが
「私、血液検査だけだったのに1時間も待たされたんですけど…」
ホントによく言われます
患者さんだけではなく
「○○さんの検査あと何分です?」って電話は
看護師さんからもよくきます…😖笑
当たり前ですが
サボっているわけでも、忘れていた訳では決してありません!!
どうしても、検査室ってブラックボックス化されがちで
患者さんもですが看護師さんや他のコメディカルもなかなか検査室に入る機会がないもので
検査をする仕事なのは知ってるけど
「機械に乗せてスイッチ押すだけって誰でも出来るじゃん!」
「患者さんが居ない時や検体がない時は何してるの?」
等など病院内外からよく言われてしまう部署なんです
その辺の話はまた今度するとして…
皆さんの血液が採血室から検査室へ搬入された後、検査結果が出るまでのブラックボックスの中を解説していきたいと思います!!
その前に、採血した時に…
〘 2本~3本もなんでそんなに採血必要なの? 〙
〘 血液そんなに採るの?😭😭〙って思いませんか?
それは、採血管によって測定できる検査項目、(採血管の中に入っている抗凝固剤)が違うからなんです
主な採血管としては
生化学(分離剤):黄色
血算(EDTA入り):紫
血糖(フッ化Na):灰
があります。それぞれ分析機器が違い検査材料が全血か血清か血漿かによっても変わります
検査室にこれらの採血管が搬送されて来たら
①受付業務
採血管の本数に間違いがないか、採血量、何時何分に検査室に搬送されたかを確認します
病院や施設によって様々ですが大体はバーコード管理されています
②血算の検体を分析機器にかけます
血算は、貧血や白血球、血小板を調べる検査です 所要時間:5分~10分
③血糖の採血管を遠心分離機(5分)にかけて血球成分と血漿を分離し血糖の分析機器で測定します血糖の他によく耳にする糖尿病の検査項目であるHbA1cの検査もこの採血管で実施します(全血) 所要時間:15分~20分
④生化学の検査では血清を使用します
そのため血液が完全に凝固するまで待ち(10~15分)、その後に遠心分離機(5分)を行います。
そして、分析機器にて測定します。(10分)
アルコールの摂取により上昇するγ-GTや
通風の原因になる尿酸値、たんぱく質などを測定します 所要時間:30~45分
他にも感染症検査や腫瘍マーカーなど検査がある場合は生化学の採血管を使用し免疫の分析機器で測定(約20分)の時間がかかります
⑤測定結果が出たら
検査技師が数値を確認し、時系列と乖離していたり、数値が異常に高い、低い場合には再検査を行います(再検査 生化学 約10分)
これを約1時間で各部門の検査技師が行っていますどうですか?裏ではこんなことをしてたんです。ただ検査機器にかけるだけではなく
遠心分離の作業があるために特に生化学・免疫検査は時間がかかります
また、異常値が出た場合には分析機器の数値が正しい値なのかどうかなどカルテやドクターに確認した上で臨床側へ報告するために時間がかかることもあります
大学病院では500~1000件/day行っています
うちの病院では100件程度です
今度、採血検査がある時は
この採血管はどの部門の検査かな?
今、何をしている所かな?
と想像してみてくださいね笑
検査室のことや検査技師のことを
書いて皆さんの理解が少しでも深まり
興味を持っていただけるといいなという気持ちで書いてみました
なんでそんなに時間がかかるんだ😡!
と怒る人が少しでも減ってくれたら嬉しいです…😭😭笑
見えないところで頑張っています臨床検査技師←
こんな感じでまた、発信して行けたらと思います、よろしくお願いします🙌🙌
臨床検査技師とは
臨床検査技師は、厚生労働大臣や都道府県知事が指定した3年もしくは4年制の臨床検査技師の専門過程修了することで、受験することができる、国家資格です。
第 66 回(2020年)臨床検査技師国家試験の結果は 受験者数は、 前年比 0.8%アップの 4,854 人。 合格者数は 4.1%ダウンの 3,472 人で、合格は 71.5%でした。
※ちなみに、看護師国家試験(2020年)合格率は89.2%(昨年89.3%)
医師の指示の下に検査を実施する仕事です
業務内容を説明すると
検体検査
・血液→貧血、白血球
微生物検査
生理検査
・心電図
・超音波
病理検査
遺伝子検査
などなど列挙しきれないほど沢山の業務がありますが働く場所によっても業務が変わります
病院や検査センター、クリニックなどの特色により大学病院などの施設では専門的な知識や資格を有すスペシャリストとして、小さな病院であれば専門部署を持たず臨機応変に全ての検査をこなす臨床検査技師もいます🙌
クリニックではMRI、採血もしたり…
近年では胚培養士も人気です
私はどちらかと言えば後者で300床程度の公立病院に勤務していて
血液検査を行いながら5領域の超音波検査をしています
もう8年目だというのに毎日のように新しい発見があり日々勉強、勉強です…
長々と書いてしまいましたが
結局何が言いたいかといいますと
超音波検査をしても、DrやNsと間違われ
検査技師と言うと
「レントゲンとかMRIとか撮る人?」と
放射線技師と間違われたり…🙄
2016年にドラマ化された
では臨床検査技師が登場しています
病理検査がピックアップされてました
手術で摘出された臓器や腫瘍などをパラフィンで包埋して3~4μm(0.003~0.004mm)の薄さに薄切して、染色をします
それを、岸先生が鏡検して診断をするわけです
切片が上手く出ていなかったり染色が悪かったりすると大変なことになります😖😖😖
実習病院で練習させてもらいましたが
一長一短でできるような技ではありませんでした
病理に携わる技師さんは、特に職人気質の方が多いイメージがあります
1人で大学病院の病理を回すのは
人間技ではありません🤔🤔
きっと森井くんは特別な訓練を受けているんですね笑
さすが、スーパー検査技師!!
漫画は、19巻まで発売されています
臨床検査技師に興味ある方はどうぞ読んでみて下さい
今なら第1巻をKindle版で無料で見ることができます
確認してみてくださいね🥰
医療従事者が読んでも、筆者の専門知識には驚かされます
自分の体験とリンクすることがあって感涙してしまったことも…
それくらい完成度高いです
患者さんのために仕事、勉強頑張ろうって改めて思いました!
このブログをきっかけに臨床検査技師を目指している方、臨床検査技師の方、他の医療従事者の方などなど繋がって行けたらいいなと思います
真面目に書くのは最初だけだと思います笑
これからは、日々の業務内容や趣味のことを
備忘録程度に書く予定です
どうぞ宜しくお願いします


![【Amazon.co.jp限定】はたらく細胞!! 1+2+3+4巻購入セット(1,2+3,4巻購入メーカー特典:「全巻収納BOX」付)(1,2+3,4巻購入オリジナル特典:「フェイスタオル」付)(通常版) [DVD] 【Amazon.co.jp限定】はたらく細胞!! 1+2+3+4巻購入セット(1,2+3,4巻購入メーカー特典:「全巻収納BOX」付)(1,2+3,4巻購入オリジナル特典:「フェイスタオル」付)(通常版) [DVD]](https://m.media-amazon.com/images/I/51Vp28IZJlL.jpg)












